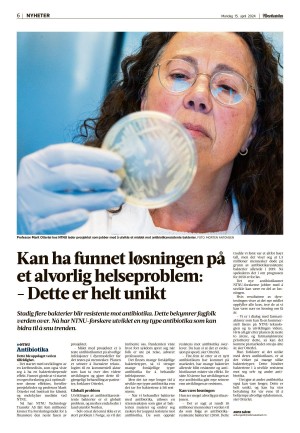
adresseavisen-20240415_000_00_00_006.pdf

Adresseavisen 4/15/24
Adresseavisen 4/15/24 is an edition of the publication Adresseavisen. The edition contains 36 pages that you can see below. The edition has 1 supplements that you can href="#pfc-supplements">see below. The PDF file of the edition is 13.84 MB. The previous edition of this publication is Adresseavisen 4/13/24. The next edition of this publication is Adresseavisen 4/16/24. Click on the publication's link Adresseavisen to see information about other editions.
The publication Adresseavisen is a newspaper and are published by the publisher Adresseavisen. The first and last edition of this publication in the archive is Adresseavisen 11/24/01 respectively Adresseavisen 2/3/26.
The archive of Adresseavisen contain 15009 editions which represents 538113 pages. All the editions are indexed in our searchable archive.

 English
English Norwegian
Norwegian Swedish
Swedish